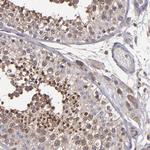
NF2 Antibody in Immunohistochemistry (Paraffin) (IHC (P))

Search
Invitrogen
NF2 Polyclonal Antibody
{{$productOrderCtrl.translations['antibody.pdp.commerceCard.promotion.promotions']}}
{{$productOrderCtrl.translations['antibody.pdp.commerceCard.promotion.viewpromo']}}
{{$productOrderCtrl.translations['antibody.pdp.commerceCard.promotion.promocode']}}: {{promo.promoCode}} {{promo.promoTitle}} {{promo.promoDescription}}. {{$productOrderCtrl.translations['antibody.pdp.commerceCard.promotion.learnmore']}}

Please note: We are reviewing Western blot images included in the antibody testing data in our catalog, including those provided by third parties. Unless expressly labeled or annotated as “raw-unedited”, Western blot images included in the antibody testing data in our catalog may have been edited, optimized or otherwise adjusted for presentation.
产品信息
PA5-82060
种属反应
已发表种属
宿主/亚型
分类
类型
抗原
偶联物
形式
浓度
规格
纯化类型
保存液
内含物
保存条件
运输条件
RRID
产品详细信息
Immunogen sequence: ERRAKQKLLE IATKPTYPPM NPIPAPLPPD IPSFNLIGDS LSFDFKDTDM KRLSMEIEKE KVEYMEKSKH LQEQLNELKT EIEALKLKER ETALDILHNE NSDRGGSSKH NTIKKLTLQS AKSRVA
Highest antigen sequence indentity to the following orthologs: Mouse - 94%, Rat - 88%.
靶标信息
NF2 encodes a protein, Merlin, that is similar to some members of the ERM family of proteins that are thought to link cytoskeletal components with proteins in the cell membrane. Merlin has been shown to interact with cell-surface proteins, proteins involved in cytoskeletal dynamics and proteins involved in regulating ion transport. This gene is expressed at high levels during embryonic development; in adults, significant expression is found in Schwann cells, meningeal cells, lens and nerve. Mutations in this gene are associated with neurofibromatosis type II which is characterized by nervous system and skin tumors and ocular abnormalities. Two predominant isoforms and a number of minor isoforms are produced by alternatively spliced transcripts.
仅用于科研。不用于诊断过程。未经明确授权不得转售。
生物信息学
蛋白别名: Merlin; MGC123124; Moesin-ezrin-radixin-like protein; neurofibromatosis 2; Neurofibromin-2; OTTHUMP00000199607; Schwannomerlin; Schwannomin
基因别名: merlin; Nf-2; NF2; SCH
UniProt ID: (Mouse) P46662, (Rat) Q63648
Entrez Gene ID: (Mouse) 18016, (Rat) 25744




